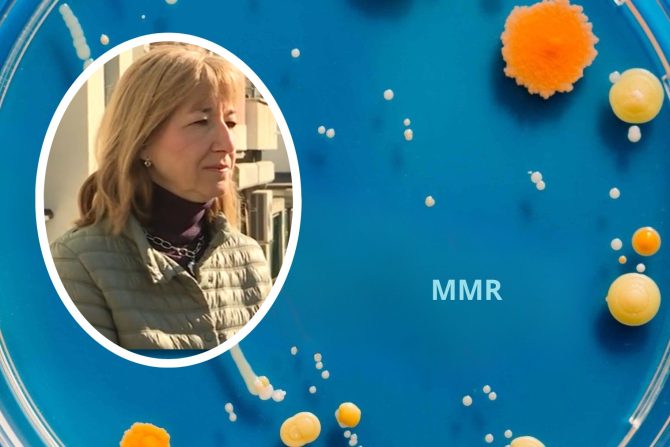
MMR

Doktorka otkriva: Koja deca ne bi smela da prime MMR vakcinu – i zašto je mnogi roditelji izbegavaju bez pravog razloga
U Beogradu je pokrenuta dopunska MMR vakcinacija za decu rođenu od 2019. do 2023. godine – bez zakazivanja i gužvi. Doktorka Ivana Begović Lazarević objašnjava zbog čega su mnogi roditelji zabrinuti, ko ne sme da primi ovu vakcinu, ali i koliko opasne mogu biti komplikacije malih boginja
U trenutku kada se u Beogradu beleže novi slučajevi malih boginja, a broj nevakcinisane dece zabrinjava lekare, stručnjaci pokreću dodatnu MMR vakcinaciju dece rođene od 2019. do 2023. godine. Cilj je jasan – podići obuhvat imunizacijom i sprečiti širenje bolesti koja može izazvati ozbiljne komplikacije. Koje su generacije u najvećem riziku, zbog čega je važan kolektivni imunitet i kako izgleda nova vakcinalna akcija – objašnjava epidemiolog dr Ivana Begović Lazarević iz Gradskog zavoda za javno zdravlje, gostujući u jutarnjem programu TV Prva.
Zašto je organizovana dodatna vakcinacija MMR vakcinom?
– Pregledom obuhvata dece MMR vakcinom u drugoj godini života i unosa podataka u poslednjih pet godina, uočili smo da je u pojedinim domovima zdravlja taj obuhvat znatno ispod očekivanih. Na teritoriji Beograda, u prošloj godini imali smo ukupan obuhvat od 90%, dok je željeni obuhvat koji obezbeđuje kolektivni imunitet 95% - na početku razgovora kaže epidemiolog dr Ivana Begović Lazarević
– U domovima zdravlja Voždovac i Lazarevac, obuhvat je oko 80%, a za decu rođenu 2019. i 2020. godine još niži. Zato smo, u saradnji sa Institutom Batut, krenuli u dopunsku vakcinaciju po principu „otvorenih vrata” - dodaje dr Begović Lazarević
Bez zakazivanja, kod bilo kog pedijatra
Roditelji ne moraju da zakazuju termin niti da vode dete kod izabranog pedijatra.
– Mogu da dođu bilo kada tokom radnog vremena i da dete vakcinišu kod bilo kog pedijatra koji u tom trenutku radi u Domu zdravlja. Na Voždovcu imamo oko 2.000 nevakcinisane dece, a u Lazarevcu oko 800. Nadamo se da ćemo najmanje 50% te dece pozivima i vakcinacijom uspeti da obuhvatimo - rekla je dr Ivana Begović Lazarević.
Vakcinacija bez zakazivanja moguća je i u drugim domovima zdravlja
Na pitanje da li je princip bez zakazivanja specifičan samo za ova dva doma zdravlja, doktorka odgovara:
– U većini domova zdravlja, nevakcinisanu decu nikada ne vraćaju ako dođu. Ukoliko dete nema kontraindikaciju – vakcina se daje odmah.
Roditeljski strah od MMR vakcine: najčešća zabluda
Roditelji koji do sada nisu vakcinisali svoju decu često navode strah od autizma kao razlog. Doktorka odgovara jasno i argumentovano:
– Većina roditelja ima dilemu i plaše se da će im dete dobiti autizam. Ta bolest, odnosno autistički spektar poremećaja, je odavno dobro dizajniranim studijama odbačena kao posledica MMR vakcine. Naučno je dokazano da ne postoji uzročna povezanost kod dece do pete godine života.
Opasne komplikacije malih boginja
Umesto da se boje vakcine, roditelji bi, kako ističe doktorka, trebalo da se plaše komplikacija koje morbile mogu izazvati:
– Klinička slika morbila može da dovede do zapaljenja pluća, upale srednjeg uha, oštećenja rožnjače, što može ozbiljno da ugrozi vid. Na hiljadu obolelih, jedan može dobiti upalu moždanih ovojnica koja, čak i ako se preživi, uvek ostavlja trajne posledice.
Epidemija već traje: više od polovine obolelih su mala deca
– Na teritoriji Beograda od decembra prošle godine prijavljena je epidemija morbila. Zabeleženo je 57 slučajeva, a skoro polovina su deca mlađa od četiri godine – i sva su nevakcinisana - upozorava dr Begović Lazarević.
Ko ne sme da primi MMR vakcinu?
Postoje određena stanja kada se vakcinacija mora odložiti:
– MMR vakcinu ne mogu da prime deca sa oslabljenim imunitetom, bilo zbog bolesti ili terapije. Takođe, akutna bolest sa temperaturom preko 38°C je kontraindikacija. Alergija na jaje nije kontraindikacija – to je mit. Prava kontraindikacija može biti jedino alergija na želatin, koji je jedan od stabilizatora u vakcini - kaže na kraju razgovora dr Ivana Begović Lazarević.
eKlinika zadržava sva prava nad sadržajem. Za preuzimanje sadržaja pogledajte uputstva na stranici Uslovi korišćenja.



Весна
Belomantilašima ništa ne verujem,oni če da odluče ko sme a ko ne da primi vakcinu,koju vakcinu,ko garantuje bezbednost bilo koje vakcine uvezene sa zapada? Da imam vlast prvo bi napravila institut za proizvodnju vakcina za potrebe Srbije,tu bi zaposlila vrhunske stručnjake koji nemaju dodira i koji su protiv szo( namerno malim slovima) ,ta organizacija nema veze sa zdravstvom več suprotno. Treba kazniti sve koji su učestvovsli u unišravanju Torlaka,sve plačenike szo, vratiti prave lekare a belomantilaše momentalno odpustiti. Verujem u efikasne i bezbedne vskcine i sigurna sam da bi Srbija mogla da ih proizvodi a uvoz vakcina sa zapada momentalno zabraniti. Bilo koju propagandu i obaveznost belomantilaških procedura ukljucujuci i vakcine momentalno zabraniti. Kada Srbija bude proizvodila vakcine verujem da če svi kao nekada sami dobrovoljno primiti vakcinu,kada sam bila dete mene je tata sam odveo da primim vakcinu( nismo bili tu kada su je druga deca primila), i to ne zbog pritiska ili obaveznosti vec zbog mog zdravlja jer smo znali da Torlak proizvodi vakcine da bi nas zaštitio od bolesti da je cilj zdravlje.
Podelite komentar
Јасна
Да ли је ризично да дете са астмом и атопијским дерматитисом, који се не повлачи, дати ммр?
Podelite komentar